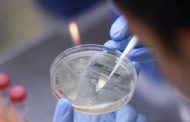
أبحاث أمريكية..

بلاحدود ـ مجلس النواب صادق مجلس النواب أمس الثلاثاء 21 أبريل 2020 بالإجماع، على مشروع قانون رقم 25.20، بسن تدابير استثنائية لفائدة المشغلين المنخرطين بالصندوق الوطني للضمان الاجتماعي والعامل... اقرأ المزيد
محمد راقي ـ بلاحدود تمكنت عناصر فرقة الشرطة القضائية لمنطقة أمن بنمسيك بمدينة الدار البيضاء، زوال اليوم الاثنين، من توقيف شخص يشتبه في تورطه في قضية تتعلق بخرق حالة الطوارئ الصحية، وعدم الام... اقرأ المزيد
عبد الله الغزلاني ـ بلاحدود في معرض حديثه حول الجرد اليومي للحالة الوبائية ببلادنا، كشف السيد اليوبي، أن طريقة تتبع المخالطين تبقى أنجع السبل للتعرف على حالات الإصابة بكورونا، موردا أنه جرى... اقرأ المزيد
بلاحدود أعلنت وزارة الصحة، أنه تم إلى حدود الساعة السادسة من مساء اليوم الثلاثاء، تسجيل 163 حالة إصابة مؤكدة جديدة بفيروس كورونا المستجد (24 ساعة)، ليرتفع العدد الإجمالي للإصابات بالمملكة إل... اقرأ المزيد
بلاحدود قررت المندوبية العامة لإدارة السجون وإعادة الإدماج، إخضاع جميع الساكنة السجنية بالسجن المحلي بورزازات، للاختبار الخاص ب”فيروس كورونا”، وذلك بعد إصابة موظفين وسجناء. وذكر... اقرأ المزيد
بلاحدود ساهمت شركة “اتصالات المغرب”، ب 150 مليار سنتيم (1،5مليارات درهم) في صندوق تدبير جائحة كورونا، وفق بلاغ صحافي للشركة اليوم الإثنين. وقالت الشركة في بلاغها الصحافي، حول الن... اقرأ المزيد
بلاحدود تدهورت أسعار النفط الأميركي المدرج في بورصة نيويورك لأول مرة في التاريخ إلى ما دون الصفر، عند انتهاء جلسة التداولات اليوم الإثنين، بسبب تخمة في المخزون، أجبرت المستثمرين على الدفع من... اقرأ المزيد
محمد راقي ـ بلاحدود يعقد مجلس النواب، يوم غد الثلاثاء، جلسة عمومية تخصص للدراسة والتصويت على مشروع قانون رقم 25.20، بسن تدابير إستثنائية لفائدة المشغلين المنخرطين بالصندوق الوطني للضمان الإج... اقرأ المزيد
بلاحدود أعلنت وزارة الصحة، أنه تم إلى حدود الساعة السادسة من مساء اليوم الاثنين، تسجيل 191 حالة إصابة مؤكدة جديدة بفيروس كورونا المستجد (24 ساعة)، ليرتفع العدد الإجمالي للإصابات بالمملكة إلى... اقرأ المزيد
بلاحدود أظهرت تجارب جديدة أجرتها وزارة الأمن الداخلي الأمريكية (DHS)، أن فيروس “كورونا المستجد” يمكن تدميره بسرعة من خلال أشعة الشمس أو الرطوبة العالية. وقد حصلت “Yahoo New... اقرأ المزيد